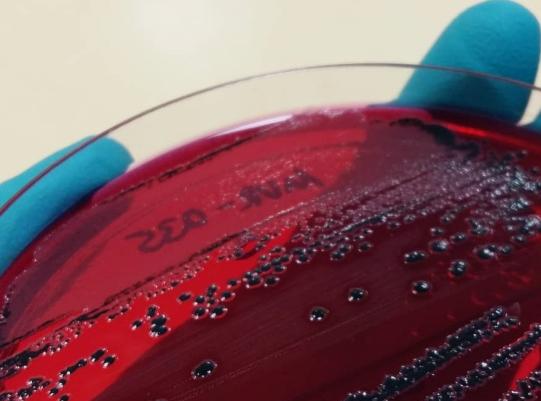
Havaneser, weiblich, 6 Monate alt

Die muntere Hündin wird uns vorgestellt, weil sie an Durchfall leidet. Ansonsten geht es ihr gut, allerdings ist sie seit jeher eine wählerische Esserin, weshalb die Besitzer schon verschiedene Hundefutter versucht haben und schlussendlich mit Rohfütterung begonnen haben.
Bild: J-N Faber
Beim Untersuch sind keine Auffälligkeiten zu bemerken - die Hündin ist vital; ihr Körperbau ist zwar schlank, aber sie ist nicht unterernährt. In einem ersten Schritt wird versucht, mittels durchfallstillenden Medikamenten dem Problem beizukommen. Nach einer knappen Woche ist der Stuhl aber immer noch wässrig; die kleine Hündin ist zwar immer noch aufgestellt und verspielt, frisst aber weiterhin schlecht.
Nun wird das Tier noch einmal untersucht und die Besitzer befragt. Die Hündin wird seit einigen Wochen geBARFT, d.h. rohgefüttert. Die dazu nötigen Futtermittel beziehen die Besitzer aus einem dafür spezialisierten Laden. Hellhörig macht uns der Umstand, dass als Eiweissquelle unter anderem auch Pouletfleisch roh verfüttert wird. Der Hund wird nun abgeklärt: Eine Blutuntersuchung zeigt keine relevanten Abnormalitäten. In einer Kotprobe wird das Labor dann aber fündig: Zwar enthält der Kot keine Parasiten, aber das durchfalleregende Bakterium Salmonella Enteritidis. Dieses ist offensichtlich verantwortlich für den Durchfall; der Hund hat sich mit grösster Wahrscheinlichkeit durch das roh verfütterte Pouletfleisch entsprechend infiziert.

Die junge Hündin erhält wieder ein normales, leichtverdauliches Fertig-Hundetrockenfutter. Entsprechend einem Antibiogramm wird über 2 Wochen ein Antibiotikum verabreicht, welches den Erreger abtötet. Schon kurze Zeit nach Futterwechsel und Beginn der Antibiose frisst der Hund wieder normal und zeigt normalen, geformten Kot.
Die Salmonellose ist beim Mensch eine bekannte Durchfallerkrankung. Jährlich werden in der Schweiz zwischen 1200 und 1500 Labornachweise gemeldet - die akuten Durchfälle werden meist durch Aufnahme von kontaminierten Lebensmittel (insbesondere Geflügelfleisch, Eier) ausgelöst. Eine gute Küchenhygiene (zB Verhindern von Kreuzkontamination von genussfertigen Speisen mit Rohfleisch, korrekte Kühlkette) und das Erhitzen von Geflügelfleisch verhindert in der Regel einen Infekt: Die Erhitzung über 70°C während 10 Minuten tötet den Erreger ab. Zahl und Typ der aufgenommenen Salmonellen entscheiden, ob Symptome auftreten oder nicht. Empfindlich sind insbesondere Kinder, ältere und kranke/immunschwache Menschen. Die Salmonellose ist in der Schweiz eine meldepflichtige Krankheit.
Hund und Katze sind gegenüber Salmonellen nicht sehr empfindlich. Insbesondere Jungtiere, welche noch kein ausgereiftes Immunsystem besitzen, können aber an Durchfall erkranken - selten entwickelt sich sogar eine schwere systemische Erkrankung mit Besiedelung von inneren Organen und Septikämien. Nimmt ein Tier Salmonellen auf, kann es aber auch zum stillen Ausscheider werden - im Kot des gesund erscheinenden Hundes werden die Erreger ausgeschieden und können andere Tiere oder den Menschen infizieren. Man schätzt, dass ca 3-5% der gesund erscheinenden Hunde Salmonellen ausscheiden. Aufgenommen werden die Salmonellen über entsprechend kontaminierte Gegenstände (zB jauchegedüngtes Gras) oder kontaminierte Futtermittel.

Bild mit freundlicher Genehmigung CDC, USA
BARF-Fütterung kann problematisch sein. Im Falle der vorgestellten Hündin ist davon auszugehen, dass die Salmonelleninfektion via die Verfütterung von rohem, zuvor gefrorenen Pouletfleisch zustande gekommen ist. Eine kürzlich publizierte Studie aus Holland fand in 20% der untersuchten BARF-Futtermittel Salmonellen.
Nicht zu unterschätzen ist diesbezüglich wie erwähnt die Tatsache, dass ein infizierter, gesund erscheinender Hund Salmonellen ausscheiden und so den Besitzer infizieren kann. Eine BARF-Fütterung in einem Haushalt mit Kindern oder immungeschwächten Personen ist deshalb nicht zu empfehlen.

Cartoon: Magazin "Titanic"
© Dr. med. vet. P. Müller / Lyssbachvet